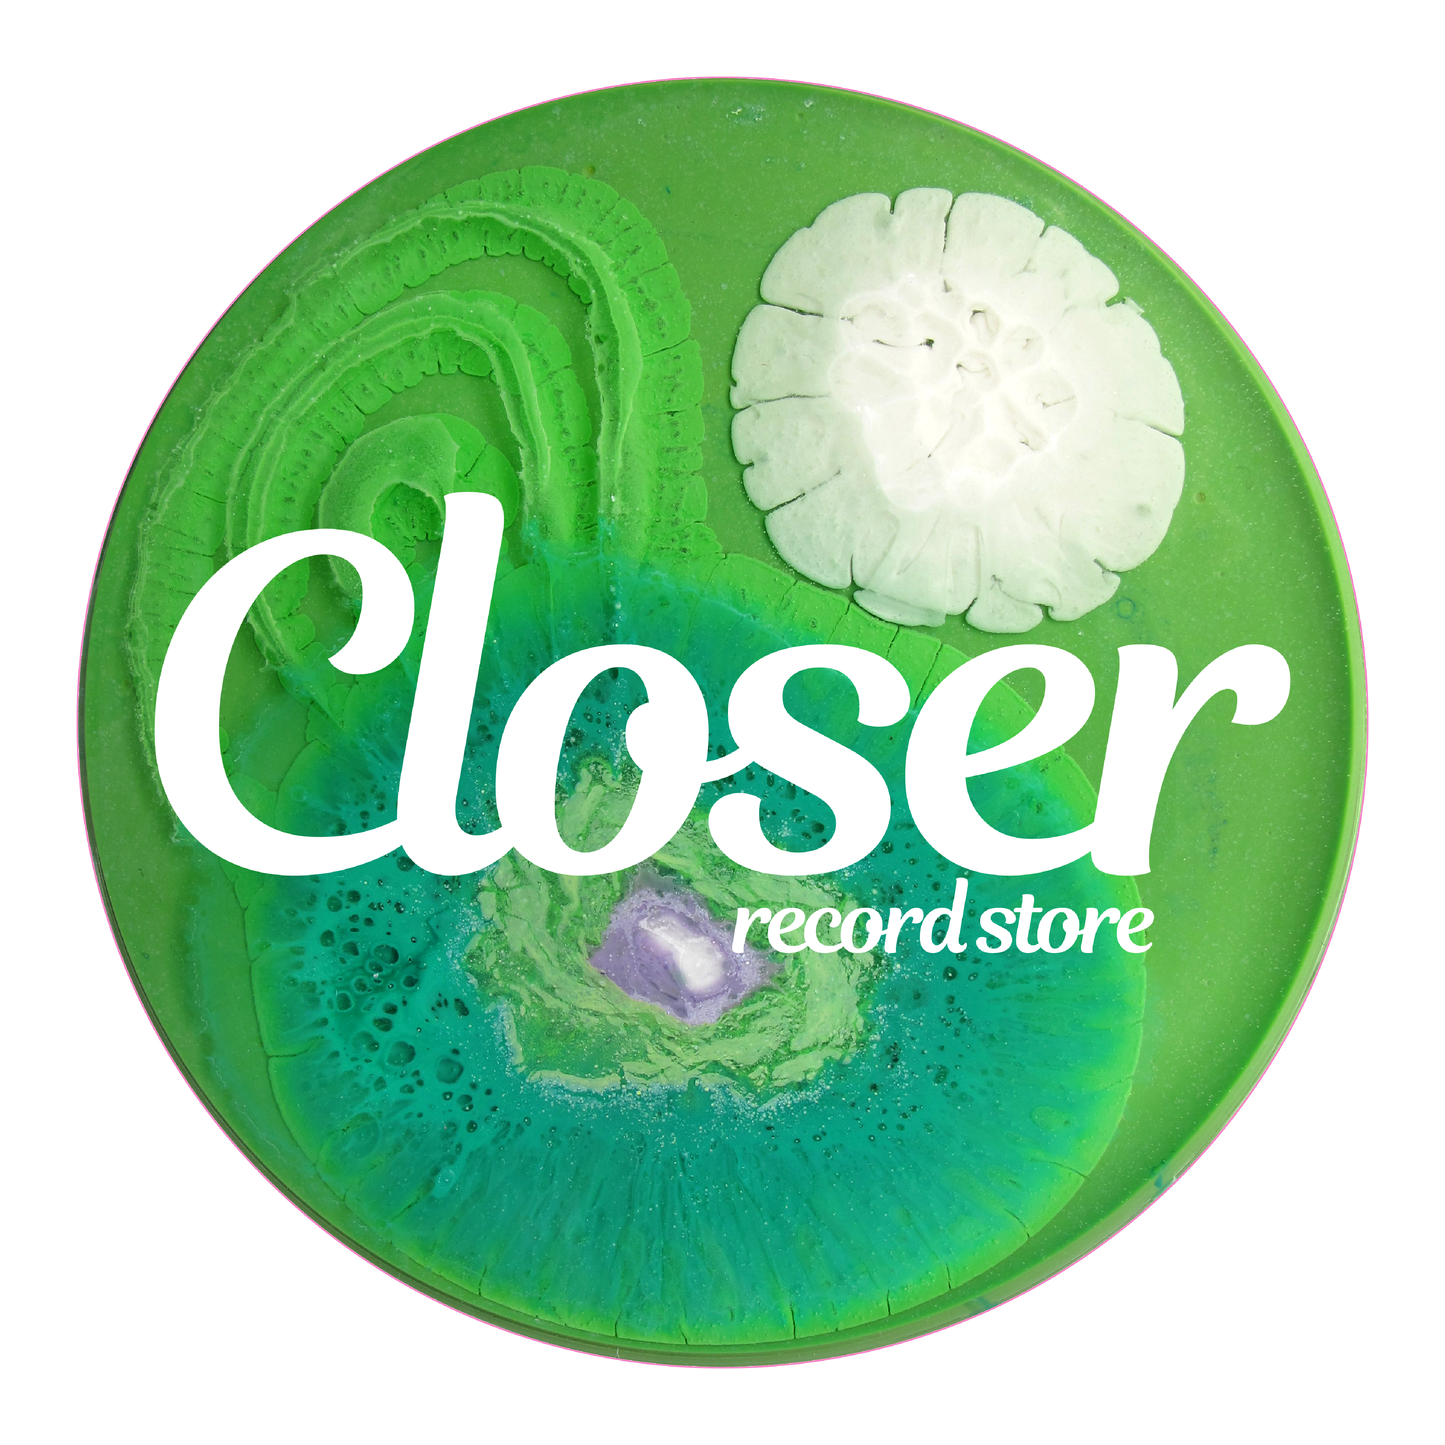

Biosonic Series Slipmats
Biosonic Series Slipmats
Regular price
$20.00 AUD
Regular price
Sale price
$20.00 AUD
Taxes included.
Shipping calculated at checkout.
Label: ()
Formats:
Style:
Quantity
Couldn't load pickup availability
00:00
🎛️ 2 for $30 Deal
Mix & match any two slipmats — discount applies automatically at checkout.